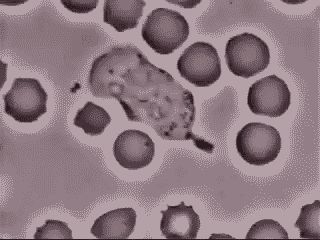

我们的城市,在“癌变”么?
本文来自微信公众号:菠萝因子(ID:checkpoint_1),作者:菠萝,标题图来自东方IC
(一)
宏观社会和微观社会其实蛮像的。
我去年走了20多个城市,发现了人类城市和癌细胞的又一个相似之处,那就是都喜欢“去分化”!
什么是“去分化”?
了解“去分化”之前,要先知道“分化”。这俩都是生物学中的重要概念。
“分化”,英文是Differentiation,直译就是“变得不同”。指的是从没有具体功能(未分化)的细胞变成有具体功能(分化)细胞。

胚胎干细胞就属于未分化的细胞。我们每个人都是从胚胎干细胞发育来的,它能产生人体所需要的所有细胞,包括肌肉细胞、红细胞、神经细胞等等。这个细胞属性的变化过程,就是“分化”。
“去分化”则刚好相反,是一个“分化”的细胞,重新变成“未分化”的细胞。比如一个神经细胞,重新变成干细胞。
正常人体中有各种各样未分化的细胞,也有各种各样分化的细胞。简单来讲,这两类细胞最大的区别是:
未分化的细胞很能生,能产生分化的细胞,但它本身不执行具体生理功能;
分化的细胞通常没有繁殖能力,但执行着身体的某项具体功能。
未分化的细胞就像蜂巢里的蜂王,每天的任务就是生生生!分化的细胞就像蜂巢里的工蜂,辛勤采蜜,保卫家园,但丧失了生育能力。
除了繁殖能力,这两类细胞的外貌也大不一样。
未分化的干细胞从长相来看,实在乏善可陈,纯粹就是路人。对比下面这两张图,要不标注,大家很难区分,哪个是血管内皮干细胞,哪个是神经干细胞。

相反,分化细胞长得则是千姿百态,甚至千奇百怪。虽然不一定都很帅,但绝对有特点,任何人一眼都能区分。一个肌肉细胞和一个免疫细胞,就像唐僧和猪八戒,绝不会搞混。
下面这个动图里出现的是实验室培养的心肌细胞。无论是细胞的短柱形状,细胞上的肌原纤维和细胞间的闰盘结构,还是独有的节律跳动能力,都毫无疑问地展示它们是分化的心肌细胞。

而下面这个正在追杀黑点(细菌)的灵活胖子,叫巨噬细胞,一种非常重要的免疫细胞。它拥有巨大的细胞体和无以伦比的灵活移动能力。它能感知细菌等病原体发出的信号,从而实现精确打击,为身体保驾护航。一眼就能认出来。
分化的本质,就是“牺牲繁殖能力,换取独特功能和长相”的过程。
人体的发育过程,基本上就是一部细胞的分化史。少量干细胞,通过生长和分化,逐渐产生各种各样的功能性细胞,组成了我们的人体。
而很多癌细胞的出现过程,和发育恰恰相反。
有些本来已经分化的细胞,由于基因突变等因素,抛弃特定功能和长相,换回生长能力,这个过程就是“去分化”。
一个正常的肠壁上皮细胞,通过去分化,变成了肠癌细胞。一个正常的乳腺上皮细胞,去分化,可以变成乳腺癌细胞。
“去分化”以后的癌细胞,重新获得了生长能力,但同时也开始丢掉自己的特性。显微镜下,一个肠壁细胞和乳腺细胞截然不同,但肠癌细胞和乳腺癌细胞,有时可以长得很类似,甚至肉眼无法区分。
有研究表明,某些肿瘤里包括一些“去分化”尤其彻底的细胞,被称为“肿瘤干细胞”。它们是导致肿瘤生长、耐药和转移的幕后黑手。
(二)
说了这么多,和人类城市有啥关系呢?
因为人类城市正在高速地“去分化”。
我们的城市曾经是高度分化的。
历史上的中国,不同城市的特征非常明显,建筑不一样,吃的不一样,穿着也不一样。
下面这张图片,一眼便知是安徽。

图:安徽宏村(图片源自网络)
明清时代,徽商称霸中国商界,如同现在的温州商人。“商贾之称雄者,江南首推徽州”。这帮人不仅有钱,而且有文化,回老家后,修建了大量高逼格的建筑。无论民居、祠堂还是牌坊,都讲究情趣和灵气。徽派建筑如同水墨画,黑白分明。黛瓦,粉璧,马头墙,世间独一无二。徽派建筑非常好认。就像看到下面这个家伙,大大的脑袋,像八爪鱼一样的张牙舞爪,我们立刻就知道,它是神经细胞。

图:神经细胞
(三)
分化的人类城市,犹如分化的细胞。每个城市都有自己的特点,适应着当地不同的环境,发挥着不同的功能,互相依赖,互相影响,组成了整个社会。
但随着时间的发展,有些城市开始“去分化”:丢掉了自己的特色,以换取快速发展和扩张。
我相信每个人应该都有感觉,现在的大城市扩张越来越快,长得越来越像!
每个城市都是同样的电梯公寓,同样的购物中心,同样的连锁餐馆。大家穿着同样的衣服,说着同样的语言,吃着同样的快餐。
这是以前的广西,宁夏和山西民居。

(图片源自网络)
这是现在的广西,宁夏和山西民居。

(图片源自网络)
你家乡的省会,是不是也长得差不多?
下面这两张图,你能看出来是哪里么?

北京?深圳?杭州?天津?南京?长沙?武汉?成都?西安?厦门?
似乎每个城市,都有一个这样的步行商业街。
这是西宁。
我正是最近到西宁出差,才开始感悟到社会“去分化”的速度。
现在的西宁,和我心中的西北已经截然不同。城里已经很难感受到“丝绸之路”和“唐蕃古道”的历史感。
只有到城外,看到东关清真大寺,丹噶尔古城这些地方,大家才能看到一丝丝它当年多民族融合产生的特点,才能确定自己真的是身处青海。
比如下图中的塔尔寺,就是当年分化的西宁留下的“遗迹”。

图:塔尔寺(图片源自网络)
就像有一次,我在显微镜下看肿瘤样本,真的分不清楚它到底是什么肿瘤,直到看到少量类似肠绒毛的东西。这是一种负责消化吸收的重要微小结构,我才恍然大悟:“哦,原来你是个‘去分化’的肠癌。”

图:正常的绒毛结构和丢失这些结构的肿瘤
临床上,专门有一类肿瘤叫做“不明来源肿瘤”。
它们是“去分化”最彻底的一类癌细胞,彻底到病理科专家在显微镜下看它们的时候,完全猜不到它们是哪里来的,因为没有任何明显的特征。这样的肿瘤治疗起来效果一般不好,因为医生不知道应该按照什么肿瘤来治,只能靠经验来猜。
遥想当年文成公主为了国家,远嫁吐蕃。
传说她从长安出发,途经西宁日月山,在苍茫的汉藏古道口,最后回头看了一眼大唐。这里和家乡完全是两个世界,后方雨打芳草萋萋,前方雪压枯草茫茫。文成公主看到日月宝镜里映出的长安美景,思绪万千,悲从中来。
但如果现在一个西安的姑娘走到西宁,生活上完全可以无缝对接。
一样的优衣库, 一样的星巴克;
一样的华为手机,一样的可口可乐。
(四)
城市去分化,不是中国的趋势,而是全人类的趋势。
这是100年前的伦敦和东京。

(图片源自网络)
这是100年后的伦敦和东京。

(图片源自网络)
全世界的大城市都在趋同。
实话实说,要不是那个富士山,我真不看不出来东京和其它大城市有啥区别。
真怕啥时候来个日本愚公,把富士山也挖了,腾出地方来修房子。
你觉得下面这是哪里?

(图片源自网络)
答案或许让你吃惊,这是肯尼亚的首都内罗毕。
虽然它还没有摩天大楼,但按照非洲的发展速度,我毫不怀疑,这座城市会和上海,东京,纽约长得越来越像。
这又是哪里?

(图片源自网络)
这是南美的厄瓜多尔。
是不是和中国好多二三线城市挺像的?
(五)
人类现代化的过程,从某种意义上,就是人类社会“去分化”的过程。
那问题来了,人类城市为什么要去分化?
我认为和癌细胞去分化的原因一样:因为这是一种个体进化优势!
一个分化的细胞,无论是红细胞,免疫细胞,还是神经细胞,虽然很有用,但有很多局限,包括功能单一,受到周围环境的密切调控,不能乱发展,而且早晚有一死,红细胞功能重要,但平均寿命只有120天。
去分化的癌细胞则不然,虽然它不再执行什么具体功能,但它在很多地方比正常细胞厉害得多,比如生长扩张迅速,不受周围环境的调控,能利用很多资源,而且还活得更久。
从个体角度来看,这绝对是一种巨大的优势。
城市也差不多。去分化以后的大城市,能更好地吸纳资源,作为个体,效率肯定更高。
1930年的北京人,吃麻辣火锅得去重庆,吃披萨得去意大利。
2000年的北京人,吃麻辣火锅就在楼下,吃披萨也在楼下。
今天的北京人,吃麻辣火锅有海底捞送到家,吃披萨有必胜客送到家。
虽然特色鲜明的四合院没了,取而代之的是千篇一律的居民楼,但不可否认,这样的城市确实越来越方便,越来越高效了。所以大家一面抱怨大城市,一面又都往大城市跑。去分化后的城市,持续吸纳周边的人力资源和自然资源,形成正向循环,越来越大。
这个过程几乎不可阻挡。
因为无论细胞,还是城市,“去分化”都是个体寻求进化优势的必然趋势。
从进化角度来看,癌细胞个体是非常厉害,正如北京上海变成了很强大的城市。
(六)
有趣的是,过去几千年,每个城市差别一直是很大的,几乎都保持了自己特点。但为什么最近各个城市开始变得越来越像?为什么这个“去分化”或者说“同质化”的速度越来越快?
因为“去分化”不是一个正常过程,需要等待。
细胞“去分化”,需要等待基因突变,而城市“去分化”,需要等待科技进步。
在科技发展到一定程度之前, 城市发展严重受到环境的限制。
所谓靠山吃山,靠水吃水,一方水土养一方人。水对于人的生存很重要,所以古代的城市基本都靠水而建。
湘西的凤凰古城,400多年前建成,沱江穿城而过。城内的青石板街道,江边的木结构吊脚楼和红色砂岩砌成的城墙,这是一座典型的分化城市:特点鲜明,资源有限,人口有限。

图:湘西凤凰(图片源自网络)
汉朝都城长安,人口约40万,即使到唐朝鼎盛之时,常住人口不过100万,已经是当时全世界规模最大的都市。古代城市发展受限,因为资源不够,包括水。
但现在世界各地的大城市,动则有上千万人。怎么办到的?
因为科技进步了。
水不够?可以南水北调。四横三纵,极大解决了北方水资源短缺问题。不仅是北京,4亿多人都从中受益。
电不够?河北、山西、内蒙这些产煤区的火力发电厂,源源不断地向北京输入能量。
正是这些进步,让北京和天津摆脱了资源的限制,迅速发展成为超大型城市,养活了上千万人。
癌细胞的“去分化”也是一样需要等待。它等待的,当然不是科学进步,而是基因突变。
一个正常细胞,没有基因突变,会受到周围环境的严密调控和限制,不能为所欲为地生长,影响周围器官和环境。
但某一天,少数细胞里突然出现了特定的基因突变,让它们获得了摆脱环境控制的能力,开始不受控制地生长。有的甚至能主动改造周围环境,来帮助自己生长,比如刺激新的血管生成,给自己的快速生长提供养料。
它们就开始癌变了。
(七)
城市去分化,本身没啥问题,但过快地出现太多资源消耗型大城市,是有风险的。
就像出现几个癌细胞其实并不可怕。但癌细胞太多就会让人担心了。
癌细胞太多之所以影响身体,一方面因为它们挤占了太多周围资源,影响了隔壁正常细胞功能,另一方面是因为人体的整体资源有限,癌细胞用太多,可能造成系统性失衡。癌症患者很多都营养不良,甚至出现“恶病质”这种全身肌肉和脂肪丢失的现象,这和癌细胞迅速生长是有直接关系的。
城市化不是问题,但现在很多城市发展过快,产生了很多的浪费。
大家都修高楼,结果出现大量鬼城。大家都造共享单车,结果带来了单车坟墓。

图:单车坟墓(本图源自网络)
我们不禁要问:现在城市“去分化”的发展速度是不是太快了?
每个癌细胞都是自私的,每一个城市也都是自私的,全世界都是如此。对一个城市来说,去分化的诱惑是如此之大,任何个人可能都很难阻止这个过程,但如果大家一起努力,或许可以放缓速度,做出更好的规划。
如此看来,西安的老城墙,苏州的老城区显得弥足珍贵。
它们不只记录着历史,记录着文化,也代表着我们对城市愈演愈烈的“去分化”趋势的一丝抵抗。
它们已经被越来越多的高楼包围,但至少给大家带来一点希望。
什么时候西安城墙没了,我们可能就"病入膏肓"了。

图:被高楼包围的西安老城墙(图片源自网络)
参考文献:
1:Dedifferentiationand reprogramming: origins of cancer stem cells. EMBO Rep. 2014 Mar; 15(3):244–253.
2:Dedifferentiation,transdifferentiation and reprogramming: three routes to regeneration. Nat RevMol Cell Biol. 2011 Feb;12(2):79-89.
本文图片均来自网络。
本文来自微信公众号:菠萝因子(ID:checkpoint_1),作者:菠萝,标题图来自东方IC
相关推荐
我们的城市,在“癌变”么?
美团与饿了么的方案,我们在他人困境中的角色
饿了么欲重启“烧钱大战”,大举进军低线城市圈地
口碑饿了么“数字化”下沉,会给三四线城市带来新增长吗?
饿了么也能送万宁化妆品保健品了 26座城市上线
北斗导航系统即将完全建成,我们的生活会因此改变么?
饿了么在批量制造“叮咚买菜”
在加拿大挑战UberEats的华人外卖公司,能从虎口夺食么?
美国版饿了么将上市,在美点外卖是种什么体验?
那些影响我们基因的微生物
网址: 我们的城市,在“癌变”么? http://www.xishuta.cn/newsview4900.html
推荐科技快讯
- 1问界商标转让释放信号:赛力斯 95792
- 2报告:抖音海外版下载量突破1 25736
- 3人类唯一的出路:变成人工智能 25175
- 4人类唯一的出路: 变成人工智 24611
- 5移动办公如何高效?谷歌研究了 24309
- 6华为 nova14深度评测: 13155
- 7滴滴出行被投诉价格操纵,网约 11888
- 82023年起,银行存取款迎来 10774
- 9五一来了,大数据杀熟又想来, 9794
- 10手机中存在一个监听开关,你关 9519
